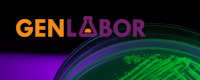
Genlabor

Sport
Bezirksmeisterschaft im Fußball
Eine Auswahl an Schülern hat am 27.11.2025 die Emil-Fischer-Schule in der Bezirksmeisterschaft im Fußball der WK I vertreten.
Schulgarten
Fortbildung zum Thema „Lerngärten“ in der Emil-Fischer-Schule
Am Dienstag, den 14. Oktober 2025, öffnete die Emil-Fischer-Schule ihre Türen, um gemeinsam mit weiteren interessierten Schulen aus dem Bezirk Reinickendorf über die Vorzüge der pädagogischen Arbeit in einem Schulgarten zu sprechen. Ziel war hierbei vor allem ein offener Austausch und gegenseitige Unterstützung bei der Konzipierung und Planung eines Schulgartens bzw. Lerngartens.
Brauerei
Sachspende des DBMB für die Brauerei 2025
In der ersten Novemberwoche überraschte uns der Deutsche Brau- und Malzmeisterbund (DBMB), Landesgruppe Berlin-Brandenburg, mit einer Sachspende.
Hauswirtschaftsklassen
Berufsschüler/-innen der Hauswirtschaft meet Vorschulkinder in der Kita Farbklecks
Am 15.10.25 haben die Hauswirtschaftsklassen aller drei Ausbildungsjahre, DHW31, DHW41 und DHW51 die Kita Farbklecks besucht und den Vormittag aktiv mit ihnen gestaltet. In der Kita haben wir gemeinsam mit den fünf- und sechsjährigen Vorschulkindern im Kindergarten verschiedene Spiele durchgeführt. Ziel des Projekts war es, die motorischen Fähigkeiten, den Tastsinn, den Gleichgewichtssinn, die Teamfähigkeit und das Wissen über die Ernährung bei den Kindern spielerisch zu fördern.
Workshops und Austausch
Pädagogischer Nachmittag an der Emil-Fischer-Schule
Am 9. Oktober 2025 fand an der Emil-Fischer-Schule ein inspirierender Pädagogischer Nachmittag statt. Dieser stand unter dem Motto „Gemeinsam Lernen und Wachsen: Vielfalt in unser Schule gestalten“ und hatte zum Ziel, eine inklusive Schulkultur zu fördern, Unterstützungsangebote der Schule zu zeigen und den Austausch zwischen Lehrkräften zu intensivieren.
Staatliche Fachschule für Lebensmitteltechnik und Vereinigung der Backbranche vdb
27. VDB-Forum Ost
Neue Wege gehen: Wie junge Bäckerinnen und Bäcker die Branche mit kreativen Unternehmenskonzepten bereichern. Die Mehlqualität aus der Getreideernte 2025 in Brandenburg.
Ein weiteres Mal konnte diese Veranstaltung unter Mithilfe der Fachschüler Bäckereitechnik der Emil-Fischer-Schule Berlin in den Räumen des Instituts für Getreideverarbeitung GmbH IGV in Nuthetahl bei Potsdam durchgeführt werden.